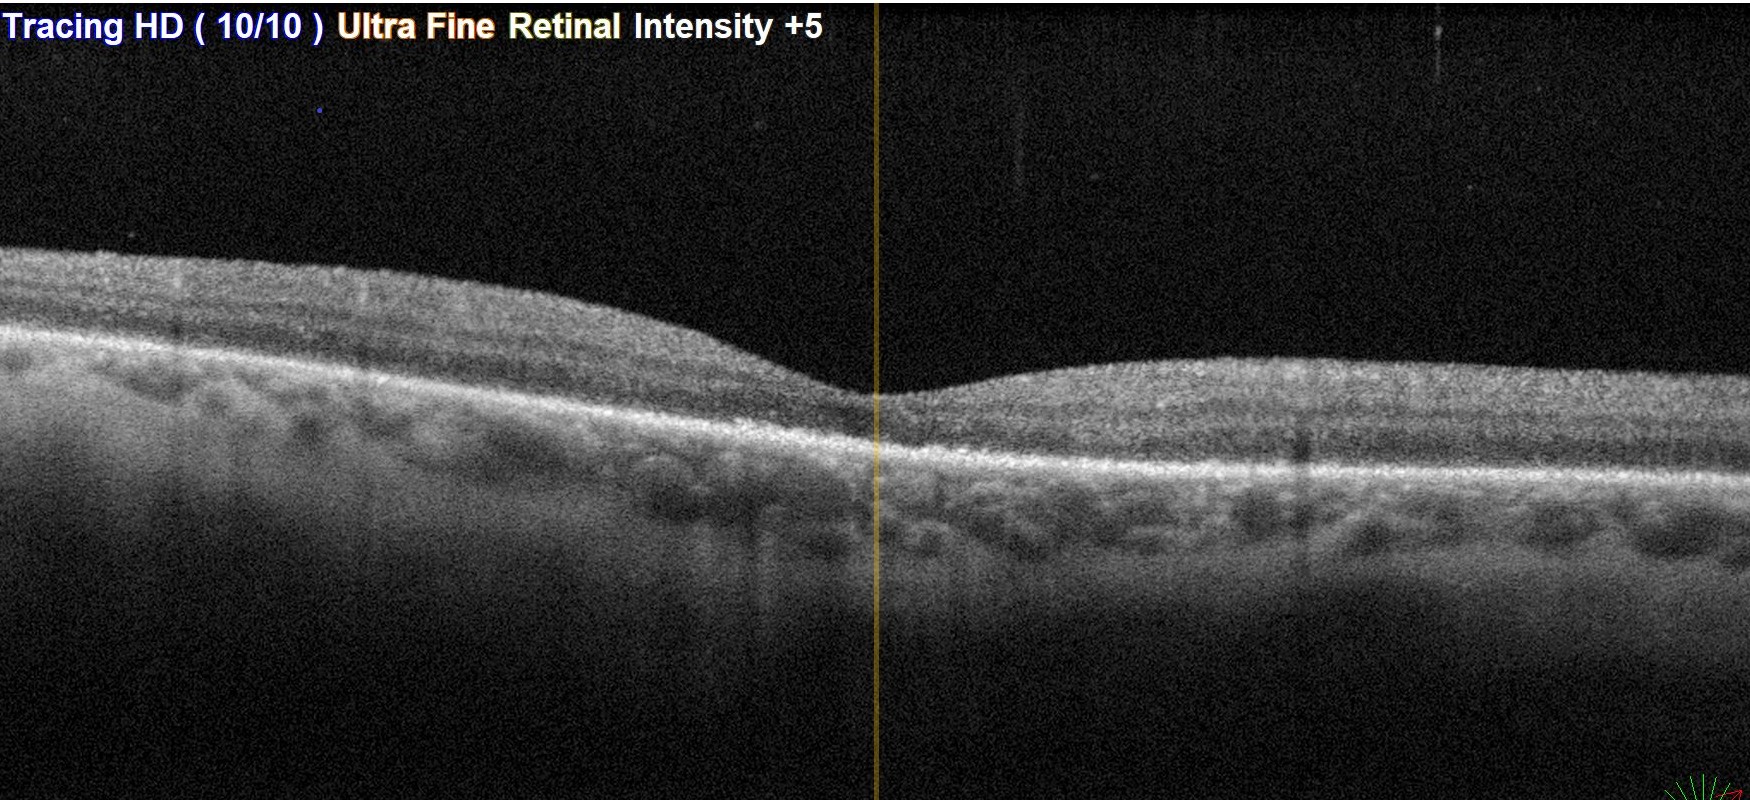
OCT dekolman

Retina dekolmanı, gözün ışığa duyarlı sinir tabakası olan retinanın altındaki dokudan ayrılmasıdır.
Retinanın normal işlevini görebilmesi ve oksijenle besin sağlayabilmesi için altındaki dokuyla temas halinde olması gerekir. Retinanın ayrışması, retinada fonksiyon kaybına; uzun sürdüğü takdirde de tedavi edilse bile kalıcı görme bozukluklarına sebep olur.
Retina dekolmanı ağrısızdır. Çoğunlukla hızlı gelişir.
Yukarıdaki belirtilerden herhangi biri olduğunda vakit geçirmeden doktora gidilmelidir. Aşağıdaki durumlarda da düzenli aralıklarla doktora gidilmelidir:
Gözün içini dolduran vitreus adı verilen jel benzeri materyel yaşla birlikte sıvı hale geçer ve bir süre sonra da arka kabuk kısmı temas halinde olduğu retinadan ayrılır. Buna arka vitreus dekolmanı adı verilir. Bun esnada ani uçuşmalar ve ışık çakmaları görülebilir. Bu ayrışmanın uyguladığı kuvvet, çevresel retinanın direncinden daha fazlaysa retinada yırtık oluşur. Oluşan bir yırtıktan göz içi sıvısının retina altına geçmesi ve retinayı giderek alttaki dokudan ayrıması ile retina dekolmanı ortaya çıkar.
Kalıtsal sebepler, miyopi ve yaş retinada incelmelere ve zaman içinde yırtık oluşumlarına neden olabilir.
Aşağıdaki faktörler retina dekolmanı riskinizi arttırır:
Gözdibi muayenesi, eğer gözdibi görülemiyorsa ultrasonografi ile konur.
Retina muayenesi: Gözdibini incelemek için parlak bir ışık ve özel bir lens (oftalmoskop) ile bir alet kullanabilir. Oftalmoskop, herhangi bir retinal delik, retina dekolmanı ve varsa ek patolojilerin görülmesine olanak tanır.
Ultrasonografi: Gözde kanama varsa retinanın ve göz içi dokuların daha iyi değerlendirilmesini sağlar.
Her iki gözün de incelenmesi gerekir.
Bir retinal yırtık veya delik içinden henüz sıvı geçişi yoksa, retina dekolmanı gelişimini önlemek ve görmeyi korumak için yırtık çevresine lazer fotokoagülasyon uygulanmalıdır.
Bu poliklinikte, ayaktan uygulanan bir işlemdir. Göz damlayla uyuşturulduktan sonra göz üzerine bir mercek temas ettirilir. Bu mercek yardımıyla lazer cihazından çıkan ışın, yırtık çevresine yönlendirilir. Lazer ışığının etkisiyle retina ile altındaki doku arasında yapışıklık sağlanarak alta sıvı geçişi önlenir.
Lazerin uygulanamadığı bazı durumlarda yırtık çevresine ameliyathane şartlarında dondurma (cryopexy) uygulaması da yapılabilir.
Prosedürden sonra birkaç hafta boyunca spordan ve aşırı bedensel faaliyetlerden kaçınmanız önerilir.
Retina dekolmanı tedavisi cerrahidir. Üç tedavi seçeneğinden biri uygulanabilir.
Göz içine gaz enjeksiyonu: Pnömatik retinopeksi adı da verilir. Yine ameliyathane şartlarında göz içine genleşebilen bir gaz enjekte edilir. Bu gazın yertığı kapatarak altında sıvı geçişini önlemesi amaçlanır. Bunun için başa belirli bir pozisyon verilerek yırtığın göz içindeki kabarcığın yırtık üzerine denk getirilmesi gerekmektedir. Bu pozisyon birkaç gün boyunca devam ettirilmelidir. Sıvı emildikten sonra yırtık çevresi lazerlenmelidir. Gaz kendi kendine emilerek bir süre sonra kaybolur.
Göz yüzeyine silikon materyellerle çökertme uygulamak: Skleral çökertme adı verilen bu prosedür, bir parça silikon materyalin etkilenen bölgenin üzerinde gözün beyaz kısmına dikilmesi ile yapılır. Bu işlem, göz duvarına girinti yapar ve vitreusun retina üzerine uyguladığı çekintiyi hafifletir.
Birden fazla yırtık, delik veya geniş bir dekolman varsa, gözün tamamını bir kemer gibi saran bir skleral bant ile göz küresi kemer gibi sıkılabilir. Bu işlem kalıcıdır.
Göz içi jelinin alınması: Vitrektomi olarak adlandırılan bu prosedür, retina üzerinde çekinti uygulayan göz içi jelini keserek uzaklaştırır. Ardından da lazer fotokoagülasyon uygulanarak retina düzleştirmeye yardımcı olmak için gaz veya silikon yağı vitreus alanına enjekte edilir.
Sonunda gaz bir süre sonra emilerek ve vitreus boşluğu tekrar sıvı ile dolar. Silikon yağı emilemediğinden birkaç ay sonra ikinci bir ameliyatla çıkartılmaldır.
Vitrektomi sklera çökertme prosedürüyle kombine edilebilir. Ameliyattan sonra iyileşme birkaç ay sürebilir. Başarılı bir tedavi için ikinci kez ameliyat gerekebilir.
Sağ gözde büyük at nalı yırtığa bağlı gelişmiş olan büllöz retina dekolmanı.Ameliyat öncesi, pars plana vitrektomi ve gaz injeksiyonundan 2 ay sonraki geniş açılı gözdibi görüntülemesi ve ameliyat sonrası maküladan alınan OCT kesiti.